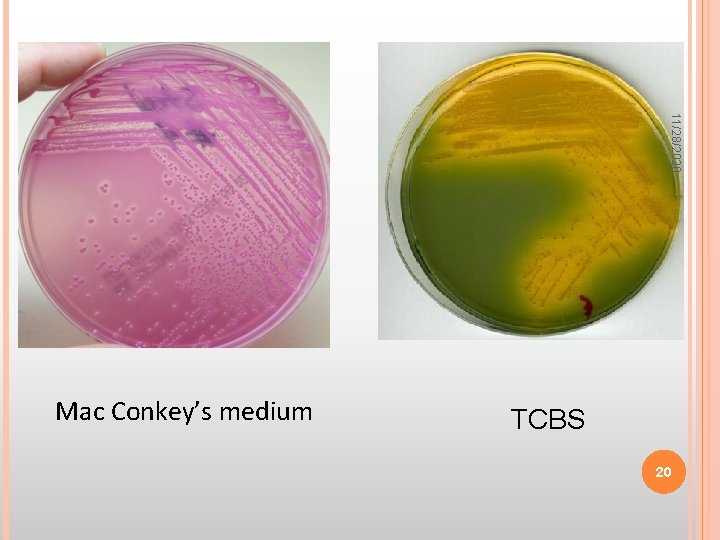
11/28/2020 Mac Conkey’s medium TCBS 20
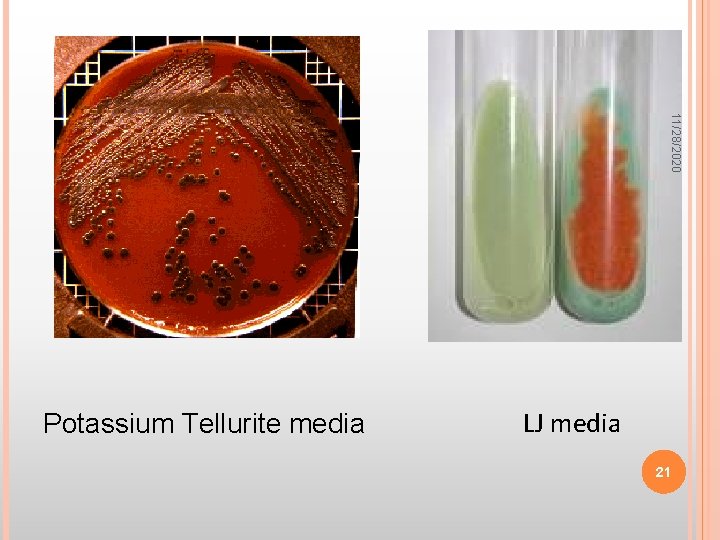
11/28/2020 Potassium Tellurite media LJ media 21

11282020 CULTURE MEDIA 1 Bacteria 11282020 have to

11/28/2020 CULTURE MEDIA 1

Bacteria 11/28/2020 have to be grown (cultured) for them to be identified. By appropriate procedures they have to be grown separately (isolated) on culture media and obtained as pure for study. History The original media used by Louis Pasteur – urine or meat broth Cooked cut potato by Robert Koch – earliest solid medium 2

11/28/2020 Colony – macroscopically visible collection of millions of bacteria originating from a single bacterial cell. Liquid medium – diffuse growth Solid medium – discrete colonies. 3

MEDIA SOLIDIFYING AGENTS 2. AGAR 11/28/2020 1. Gelatin • not satisfactory • liquefies at 24ºC 4

11/28/2020 Agar Frau Hesse Used for preparing solid medium Obtained from seaweeds. No nutritive value Not affected by the growth of the bacteria. Melts at 98ºC & sets at 42ºC 2% agar is employed in solid medium 5

TYPES OF CULTURE MEDIA Based on their consistency a) solid medium b) liquid medium c) semi solid medium II. Based on the constituents/ ingredients a) simple medium b) complex medium c) synthetic or defined medium d) Special media 11/28/2020 I. 6

on Oxygen requirement - Aerobic media - Anaerobic media 11/28/2020 Special media Enriched media Enrichment media Selective media Indicator media Differential media Sugar media Transport media Media for biochemical reactions III. Based 7

11/28/2020 Solid media – contains 2% agar Colony morphology, pigmentation, hemolysis can be appreciated. Eg: Nutrient agar, Blood agar Liquid media – no agar. For inoculum preparation, Blood culture, for the isolation of pathogens from a mixture. Eg: Nutrient broth Semi solid medium – 0. 5% agar. Eg: Motility medium 8

11/28/2020 SOLID LIQUID SEMI SOLID 9

11/28/2020 10

11/28/2020 Aseptically pouring agar plates 11

11/28/2020 Simple media / basal media - Eg: Nutrient Broth, Nutrient Agar - NB consists of peptone, meat extract, Na. Cl, - NB + 2% agar = Nutrient agar 12

11/28/2020 NONPIGMENTED COLONIES RED PIGMENTED COLONIES 13 GREEN PIGMENTED COLONIES YELLOW PIGMENTED COLONIES

11/28/2020 Complex media Media other than basal media. They have added ingredients. Provide special nutrients Synthetic or defined media Media prepared from pure chemical substances and its exact composition is known Eg: peptone water – 1% peptone + 0. 5% Na. Cl in water 14

11/28/2020 Enriched media Substances like blood, serum, egg are added to the basal medium. Used to grow bacteria that are exacting in their nutritional needs. Eg: Blood agar, Chocolate agar 15

11/28/2020 Blood agar Chocolate agar 16

11/28/2020 Enrichment media Liquid media used to isolate pathogens from a mixed culture. Media is incorporated with inhibitory substances to suppress the unwanted organism. Eg: Selenite F Broth – for the isolation of Salmonella, Shigella Alkaline Peptone Water – for Vibrio cholerae 17

11/28/2020 Selective media The inhibitory substance is added to a solid media. Eg: Mac Conkey’s medium for gram negative bacteria TCBS – for V. cholerae LJ medium – M. tuberculosis Wilson and Blair medium – S. typhi Potassium tellurite medium – Diphtheria bacilli 18

11/28/2020 TCBS AGAR – FOR VIBRIO CHARCOAL AGAR – FOR BORDETELLA 19 DCA – FOR SALMONELLA MSA – FOR STAPH
11/28/2020 Mac Conkey’s medium TCBS 20
11/28/2020 Potassium Tellurite media LJ media 21

11/28/2020 Indicator media These media contain an indicator which changes its colour when a bacterium grows in them. Eg: Blood agar Mac Conkey’s medium Christensen’s urease medium 22

11/28/2020 GAMMA HEMOLYSIS BETA HEMOLYSIS (clear zone around colonies) ALPHA HEMOLYSIS WITH GREENISH DISCOLORATION (no clear zone around colonies) 23

11/28/2020 24

11/28/2020 Urease medium 25

11/28/2020 Differential media A media which has substances incorporated in it enabling it to distinguish between bacteria. Eg: Mac Conkey’s medium Peptone Lactose Agar Neutral red Taurocholate Distinguish between lactose fermenters & non lactose fermenters. 26

Lactose fermenters – Pink colonies Non lactose fermenters – colourless colonies 11/28/2020 27

11/28/2020 Sugar media Media containing any fermentable substance. Eg: glucose, arabinose, lactose, starch etc. Media consists of 1% of the sugar in peptone water. Contain a small tube (Durham’s tube) for the detection of gas by the bacteria. 28

11/28/2020 29

11/28/2020 Transport media Media used for transporting the samples. Delicate organisms may not survive the time taken for transporting the specimen without a transport media. Eg: Stuart’s medium – non nutrient soft agar gel containing a reducing agent: Gonococci Buffered glycerol saline – enteric bacilli Alkaline peptone water: V. cholerae 30

11/28/2020 Anaerobic media These media are used to grow anaerobic organisms. Eg: Robertson’s cooked meat medium, Thioglycolate medium. 31

BIOCHEMICAL TEST & REACTIONS 11/28/2020 THEY PROVIDE ADDITIONAL INFORMATION FOR THE IDENTIFICATION OF THE BACTERIUM. THE TESTS INCLUDE: • TRIPLE SUGAR IRON AGAR (TSI) • CITRATE UTILIZATION • UREASE TEST 32

11/28/2020 TRIPLE SUGAR IRON AGAR (TSI) It is a composite media used to study different properties of a bacterium – sugar fermentation, gas production and H 2 S production. It contains 3 sugars – glucose, lactose, sucrose. The iron salt – ferric citrate Phenol red is the indicator. It is an orange red medium with a slant and a butt. 33

11/28/2020 34

11/28/2020 INDOLE TEST Used to detect indole production by the organism. They produce indole from tryptophan present in Tryptophan broth Positive indole test – pink ring Negative indole test - yellow ring Indole positive – E. coli Indole negative – Klebsiella, Salmonella. 35

11/28/2020 36

11/28/2020 CITRATE UTILIZATION Done in Simmon’s Citrate medium. To detect the ability of certain bacteria to utilize citrate as the sole source of carbon. Citrate positive – blue colour Citrate negative – green colour Positive – Klebsiella Negative – E. coli 37

11/28/2020 UREASE TEST Done in Christensen’s urease medium. Urease produced by the organisms split urea into ammonia and CO 2. Urease positive – pink colour Urease negative – yellow colour Positive – Proteus, Klebsiella Negative – E. coli, Salmonella 38

MULLER HINTON AGAR FOR ANTIBIOTIC TESTING 11/28/2020 39

BLOOD CULTURE –‘LIQUID MEDIUM 11/28/2020 40

NAME THE MEDIA 11/28/2020 CHOCOLATE AGAR 41

NAME THE MEDIA 11/28/2020 LJ MEDIUM 42

WHICH ONE OF THE FOLLOWING IS A INDICATOR MEDIUM? 11/28/2020 A 1. 2. 3. 4. A & B only A & C only All of the above D only B C D 43

11/28/2020 THANK YOU 44
- Slides: 44